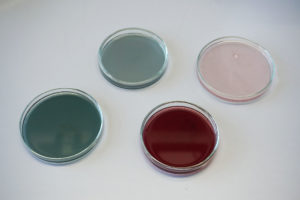

Vorkoster
Wie können wir Lebensmittelverschwendung verhindern?
Die EU-Gesetzgebung besagt, dass die meisten verpackten Lebensmittel mit „Verfalls-“ oder „Mindesthaltbarkeitsdaten“ gekennzeichnet sein müssen. Diese Angaben sind hilfreich und wichtig, doch besonders das Mindesthaltbarkeitsdatum wird oft falsch interpretiert und kann zur Verschwendung von Lebensmitteln führen.
„Vorkoster“ ist ein Deckel, der den Verfall von Lebensmitteln sichtbar macht. In seiner Mitte befindet sich eine PH-sensitive Folie, die auf das Verderben von proteinhaltigen Lebensmitteln mit einem Farbwechsel reagiert. So entsteht ein Objekt, das uns unaufdringlich und analog daran erinnert, Lebensmittel zu konsumieren, bevor es zu spät ist. Der „Vorkoster“ soll eine Alternative zum standardisierten Verfallsdatum bieten und Hilfestellung für eine unverpackte Zukunft sein.
Das Projekt wurde als Open Source Konzept entworfen, daher lag der Fokus auf der Zugänglichkeit der verarbeiteten Materialien und Herstellungsprozesse. Der Deckel ist als 3D Druck Objekt angelegt und ist daher in seiner Materialität flexibel. Die PH-Folie wurde aus Algen hergestellt und funktioniert mit einem selbst gewonnen natürlichen Indikator Farbstoff. Seine Form ist eine Hommage an den umgedrehten Teller, der gerne zweckentfremdet zur Bedeckung von Essen genutzt wird.
„Vorkoster“ basiert auf dem Gedanken, sich unabhängig von Vorgaben großer Industrien zu machen. Der Versuch, festgesetzt erscheinende Prozesse zu Demokratisieren.
How can we prevent food waste?
EU legislation states that most packaged food must be labelled with “ expiration“ or „best before“ dates. This information is helpful and important, but the best-before date in particular is often misinterpreted and can lead to unnecessary food waste.
„Vorkoster“ is a lid that makes the expiry of food visible. In its centre is a pH-sensitive foil that reacts to the spoilage of protein-containing foods with a change of colour. This creates an object that reminds us in an unobtrusive and analogue way to consume food before it is too late. The „Vorkoster“ is intended to offer an alternative to the standardised expiry date and to provide assistance for an unpackaged future.
The project was developed as an open source concept, focusing on the accessibility of the used materials and manufacturing processes. The lid is designed as a 3D printed object and is therefore flexible in its materiality. The pH foil was made from algae and works with a self-generated natural indicator dye. The shape is an homage to the upside-down plate often used to cover food leftovers.
„Vorkoster“ is based on the idea of becoming independent from the directives of large industries. The attempt to democratise processes that seem fixed.
direct to ACKNOWLEDGEMENTS

Betreut durch
Prof. Ineke Hans, Antonia Kühne, Prof. Dr. Michelle Christensen & Prof. Dr. Florian Conradi, Dr. Ruben R. Rosencrantz, Sany Chea